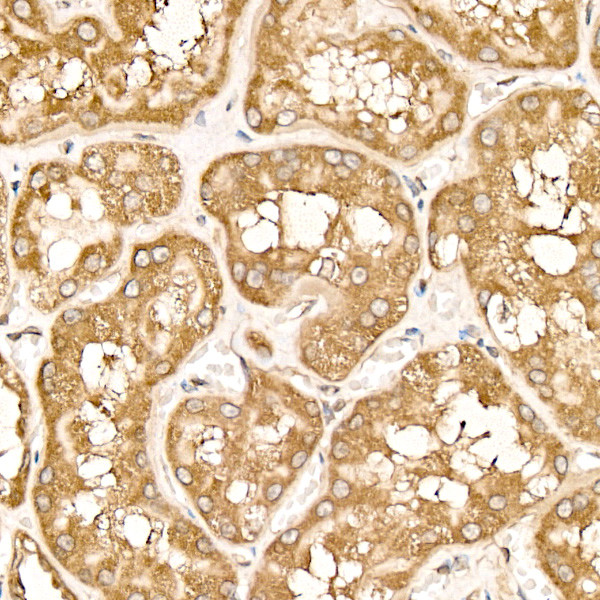
METTL4 Antibody in Immunohistochemistry (Paraffin) (IHC (P))

Search
Invitrogen
METTL4 Recombinant Rabbit Monoclonal Antibody (9N4K4)
{{$productOrderCtrl.translations['antibody.pdp.commerceCard.promotion.promotions']}}
{{$productOrderCtrl.translations['antibody.pdp.commerceCard.promotion.viewpromo']}}
{{$productOrderCtrl.translations['antibody.pdp.commerceCard.promotion.promocode']}}: {{promo.promoCode}} {{promo.promoTitle}} {{promo.promoDescription}}. {{$productOrderCtrl.translations['antibody.pdp.commerceCard.promotion.learnmore']}}
图: 1 / 2
METTL4 Antibody (MA5-55486) in IHC (P)


产品信息
MA5-55486
种属反应
宿主/亚型
Expression System
分类
类型
克隆号
抗原
偶联物
形式
浓度
规格
纯化类型
保存液
内含物
保存条件
RRID
产品详细信息
Immunogen Sequence: MSVVHQLSAG WLLDHLSFIN KINYQLHQHH EPCCRKKEFT TSVHFESLQM DSVSSSGVCA AFIASDSSTK PENDDGGNYE MFTRKFVFRP ELFDVTKPYI TPAVHKECQQ SNEKEDLMNG VKKEISISII GKKRKRCVVF NQGELDAMEY HTKIRELILD GSLQLIQEGL KSGFLYPLFE KQDKGSKPIT
靶标信息
METTL4 gene ontology annotations related to this gene include methyltransferase activity; nucleic acid binding.
仅用于科研。不用于诊断过程。未经明确授权不得转售。
篇参考文献 (0)
生物信息学
蛋白别名: methyltransferase like 4; Methyltransferase-like protein 4; N(6)-adenine-specific DNA methyltransferase METTL4; N(6)-adenine-specific methyltransferase METTL4; snRNA (2'-O-methyladenosine-N(6)-)-methyltransferase METTL4; unnamed protein product
基因别名: 2410198H06Rik; A730091E08Rik; AV296509; HsT661; METTL4; RGD1306451
UniProt ID: (Human) Q8N3J2, (Mouse) Q3U034
Entrez Gene ID: (Human) 64863, (Mouse) 76781, (Rat) 316731